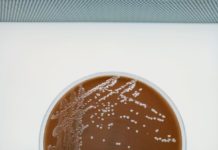
A Meningococcal Disease Outbreak Is Killing Gay And Bi Men In Florida – IFLScience

Suns basketball operations executive Ryan Resch announces he is gay – USA TODAY
Phoenix Suns executive Ryan Resch announced he is gay in an article published by ESPN.com, becoming the first openly gay person in NBA history to work basketball operations in a front office.The 29-year-old...
Looking backward: The Supreme Court turns to history books to redefine rights on abortion,...
What personal rights, such as the right to abortion, are protected by the Fourteenth Amendment’s guarantees of liberty and equality? According to the Supreme Court, only those rights that are “deeply...
How 2SLGBT people are reclaiming their faith and redefining their relationship with spirituality –...
The week Mitchell Anderson publicly came out as gay, he also attended a Sunday service in his hometown for the first time. Anderson was nervous heading to church, since personal news (and gossip)...
‘Iranian-Norwegian’ terrorist kills two in attack on gay bar: Moment suspect is arrested –...
Two people were killed and 21 injured after a suspected terrorist gunned down clubbers at an LGBT+ hotspot in Oslo last night.An Iranian Norwegian suspect, 42, has been charged with murder,...
On This Day: India won 1983 World Cup and Emergency was declared in 1975...
1 / 15 1932 | India played its first official cricket Test match against England at the Lord's ground. England won by 158 runs. (Image: Wiki Commons)2 /...
Abortion ruling draws mixed reaction in Orange County – Spectrum News 1
SANTA ANA (CNS) — Reaction to the U.S. Supreme Court's ruling overturning abortion rights Friday fell along partisan lines in Orange County Friday, with Democratic leaders condemning it and Republicans praising it.Orange...
Two dead, several seriously hurt in gun attack on gay bar in Oslo where...
Two people have been killed and several seriously wounded in a shooting at a nightclub in Norway, police have confirmed. Video on social media shows emergency services outside London Pub, a gay...
American Diabetes Association, June 3-7 – Consumer Health News | HealthDay – HealthDay News
The annual meeting of the American Diabetes Association was held this year from June 3 to 7 in New Orleans and attracted more than 15,000 participants from around the world,...
Smells Like Friendship: Similar Body Odors May Draw Folks Together – HealthDay News
FRIDAY, June 24, 2022 (HealthDay News) -- You and your best friend may have your noses to thank in helping bring you together, a new study suggests.Researchers found that pairs of...
NYC clinic offering monkeypox vaccine to gay and bi men forced to close due...
New York City officials have come under fire for a botched rollout of moneypox vaccines for at-risk gay and bisexual men just two days before Pride — amid fears festivities for the...
Florida Meningococcal Disease Outbreak: CDC Urges Gay Men To Get Vaccine – Newsweek
The U.S. Centers for Disease Control and Prevention and the Florida Department of Health are urging men who have sex with men to get vaccinated for meningitis amid "one of the...
Applied behaviour analysis,: A response to recent controversies – Monash Lens
Working with families and children who have participated in applied behaviour analysis-based therapy programs in Australia is immensely rewarding. Through our ongoing research exploring the lived experiences of families who have...
A Meningococcal Disease Outbreak Is Killing Gay And Bi Men In Florida – IFLScience
Meningococcal disease refers to any illness caused by bacteria called Neisseria meningitidis. Image credit: TheBlueHydrangea/Shutterstock.comOne of the worst outbreaks of meningococcal disease among gay and bisexual men in US history has...
Regional birds sent to lab to be tested for avian flu – The Nome...
By Megan GannonLast Friday morning, Gay Sheffield was packing a cooler in the science lab at the University of Alaska Fairbanks’ Northwest Campus in Nome. She was not preparing for a...
BLM Welcomes Jason Gay as High Desert District Manager – SweetwaterNOW
ROCK SPRINGS —The Bureau of Land Management welcomes Jason Gay as the new district manager for the High Desert District of Wyoming. As district manager, Gay manages approximately 9.6 million acres...
Gay Science’s Rob Anderson On How He Approaches Music And Comedy – Exclusive –...
Comedy and music are quite different, but for Rob Anderson, they deserve and need the same amount of attention to detail. In fact, on his approach to the two, he told...
If scientists don’t share their data, how can we trust them? – iNews
This is Geek Week, my newsletter about whatever nerdy things have happened to catch my eye over the past seven days. Here’s me, musing about something I don’t fully understand in...
‘Unscientific’ trans sports bans will ‘deny trans kids a childhood’, experts say – PinkNews
International rugby officials restricting trans ruggers will negatively impact society, trans activists warn. (Stu Forster/Getty Images) Trans sports bans and restrictions won’t...
Monkeypox: How to protect yourself against the virus – DW (English)
Monkeypox infections have been registered in more than 40 countries, including the United Kingdom, Germany and Spain. In response, the World Health Organization summoned an emergency meeting on June 23, where...
Nietzsche: your conscience is no saint | Christopher Janaway – IAI
Isn’t it strange that we all have that little voice in our heads that continually deciphers good from evil? We often think our conscience is something close to a perfect moral...
CDC Moves To Expand US Monkeypox Testing Capacity – Kaiser Health News
The Biden administration will allow commercial labs to conduct monkeypox testing, as the case count exceeds 150 in the U.S. Meanwhile, the World Health Organization considers declaring the...
First Edition: June 23, 2022 – Kaiser Health News
Today's early morning highlights from the major news organizations. KHN: Trump’s Legacy Looms Large As Colorado Aims To Close The Hispanic Insurance Gap Armando...
Defying Russia’s ‘gay propaganda’ law to set up an LGBTIQ museum – Open Democracy
openDemocracy: How did you come up with the idea for your collection and museum?Pyotr Voskresensky: I am not a professional historian, but I have been interested in history all my life....
Comedian Rob Anderson blinds us with Gay Science and answers … – Socialite Life
Rob Anderson is a comedian, LGBTQ+ social media star and bestselling author. His viral series “Gay Science” uses comedy to dispel erroneous beliefs about the LGBTQ+ community and empower marginalized groups.His...
Florida Sen. Rick Scott criticized the Texas GOP’s official stance on homosexuality being ‘abnormal,’...
Sen. Rick Scott of Florida.AP Photo/Andrew Harnik, FileThe Texas GOP platform calls being gay "abnormal" and says Biden wasn't "legitimately elected."Sen. Rick Scott said the language wasn't "inclusive" and acknowledged Biden's...
Sen. Rick Scott says Texas GOP stance on homosexuality not ‘inclusive’ – Business Insider
The Texas GOP platform calls being gay "abnormal" and says Biden wasn't "legitimately elected." Sen. Rick Scott said the language wasn't "inclusive" and acknowledged Biden's win. A gay Republican group...
Letter: Flying the flag with pride – Mountain View TODAY
To the likely discomfort of my neighbours, I have taken to flying the GAY PRIDE flag in my yard, during the month of June, also known as PRIDE month. The...
Is the LGBT Community Doing Enough to Fight Monkeypox? – POZ
“Monkeypox is not a gay disease.” “Anyone can get monkeypox.” We’ve heard this ad infinitum—and it’s accurate—but in as we attempt to avoid stoking stigma and homophobia, I fear the LGBT...
WFU in the news: June 13-19 | Wake Forest News – Wake Forest News
FEATURED NEWS
The great pollen meltdown
By Carolyn Beans | The Food & Environment Reporting Network (FERN)At stake is much of our diet. Every seed, grain, and fruit that we eat is a...
Real-Life Must-Reads: Nonfiction Authors’ Favorite Titles for Young People – School Library Journal
Author and illustrator Robin Ha (Cook Korean!) recommends “March” by John Lewis and Andrew Aydin, illus. by Nate Powell, which she calls "most influential"; Maus:...
Mat Johnson Invisible Things book review – The Washington Post
Placeholder while article actions loadBack in 2011, I reviewed Mat Johnson’s “Pym,” a wildly entertaining seriocomic novel that revisits — and updates — Edgar Allan Poe’s enigmatic, racially charged fantasy, “The...
Hitting the road this summer? Here are 12 gripping podcasts to take with you....
AdvertisementIf we were making the same trek today, it’d be infinitely more enjoyable, in part because my father and I have a better relationship than we did when I was a...
15 leaders giving voice and visibility to the LGBTQ community in biopharma – Endpoints...
Most food allergy care involves avoidance — checking ingredient labels, no peanut tables in schools, and so on. However, that paradigm has been shifting with oral immunotherapies, or OITs for short,...
Monkeypox jab be given to at-risk gay, bisexual men, says UK report – Business...
Some gay and bisexual men, who are at a higher risk of contracting monkeypox, should be offered a vaccine, say the UK health officials.
AdvertisementAccording to the BBC, this could help to...